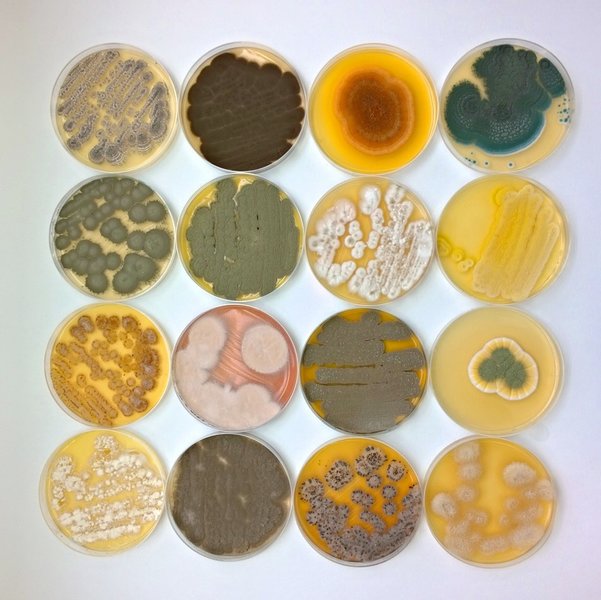
Ansicht von Pilzkulturen in Schalen

Ausschnitt aus einem Chromatogramm einer automatischen DNA-Sequenzierung
Bild: M. Piepenbring
Was ist ein/e Fachberater/in für Mykologie?
Fachberater für Mykologie univ. gepr.
Bei der Ausbildung zum universitätsgeprüften Fachberater für Mykologie werden im Rahmen von acht Modulen Kenntnisse zur Systematik, Ökologie, Biotechnologie, Phytopathologie, Lebensmitteltechnologie, Genetik und medizinischen Bedeutung von Pilzen vermittelt. Diese Module werden überwiegend von Professoren an Universitäten in Deutschland geleitet.
Durch die Teilnahme an diesen Modulen, das Bestehen einer universitären Abschlussprüfung und die Anfertigung eines Prüfungsgutachtens werden die Teilnehmer zum Fachberater für Mykologie ausgebildet und sind dadurch in der Lage, beratend und forschend in verschiedenen Zusammenhängen Dienstleistungen zu erbringen.
-
Studien- und Prüfungsordnung zum universitär geprüften Fachberater für Mykologie (Stand 14.3.2023)
Studien- und Prüfungsordnung zum universitär geprüften Fachberater für Mykologie (Stand 14.3.2023)
Aufgabenprofil
Die Einsatzmöglichkeiten und Tätigkeiten eines Fachberaters für Mykologie sind vielfältig und sowohl gesundheits- als auch umweltpolitisch relevant.
Die Bestimmung von Pilzen ist eine deutlich schwierigere Aufgabe als die Bestimmung von Pflanzen. Daher ist eine solide Ausbildung bezüglich Pilzartenkenntnis nötig, um den Anforderungen eines Fachberaters für Mykologie gerecht zu werden. Darüber hinaus erhalten die Teilnehmer einen Einblick in die physiologischen Eigenschaften von Pilzen.
Entsprechend der Diversität der Pilze, der Vielfalt ihrer Lebensräume, ihrer Stoffwechselwege und ihrer Interaktionen sind auch die Einsatzmöglichkeiten des Fachberaters für Mykologie vielfältig:
- im Pflanzenschutz,
- in der Forstpathologie,
- im Naturschutz (Erstellung naturschutzfachlicher Gutachten),
- in Zusammenarbeit mit Kliniken bei Vergiftungsfällen,
- in der medizinischen Mykologie,
- in der Gebäudemykologie,
- in der Biotechnologie,
- in der Pilzzucht,
- in der Industrie, im öffentlichen Dienst oder freiberuflich.
Bilder
-

Fermenter zur Kultivierung von Pilzen
Bild: M. Piepenbring
-
Bunte (Pilz-)Kulturenvielfalt
Bild: Anja Schüttler
Fachberater Koordination
Teilnahmevoraussetzung
- Vier Semester erfolgreiches Studium der Biologie oder einem verwandten Fach an einer Hochschule
ODER
- eine vergleichbare Qualifikation
ODER
- Bestehen einer Eingangsklausur zu allgemeinem biologischem Wissen.
Zulassungsverfahren
Wenn Sie Interesse an der Teilnahme haben, schicken Sie ein entsprechendes Schreiben an die Koordinatorin. Der Einstieg ist jederzeit möglich.
Dauer der Ausbildung
Jedes der acht Module (vgl. Innenseiten des Flyers) dauert in der Regel fünf Tage vor Ort und umfasst Vor- und Nacharbeit. Jedes Modul wird ein Mal pro Jahr angeboten. Es ist also theoretisch möglich, die Ausbildung innerhalb von 2–3 Jahren abzuschließen. Sie entscheiden selbst, welche Module Sie wann belegen, und können so individuell die Dauer Ihrer Ausbildung steuern.
Koordination

Hermine Lotz-Winter
Bild: DGfM Archiv
Koordinatorin: Hermine Lotz-Winter
Prüfungskommission

Prof. Dr. Meike Piepenbring
Bild: DGfM Archiv
Vorsitzende: Prof. Dr. Meike Piepenbring
Module
Im Rahmen des Moduls „Systematik und Ökologie der Pilze (Einführung)“ werden wichtige Grundkenntnisse zu Pilzen vermittelt. Typische Strukturmerkmale ausgewählter Pilzgruppen werden erklärt und an Beispielarten beobachtet. Zudem werden wichtige ökologische Aspekte thematisiert, insbesondere Mykorrhizen und Flechten. Die lichtmikroskopische Untersuchung ist für eine sichere Bestimmung der Mehrzahl der Pilzarten unverzichtbar, daher wird dieses Modul als Einstieg empfohlen.

Hymenium mit braunen Basidosporen
Bild: M. Piepenbring
In dem Modul „Artenkenntnis, Naturschutz und Toxikologie“ wird fundierte Artenkenntnis und ökologisches Wissen vermittelt. Durch eine Schwerpunktbildung im Bereich der Artenkenntnis von Großpilzen und Toxikologie kann bei der Bewertung von Vergiftungen durch Verzehr vermeintlicher Speisepilze professionelle Hilfe geleistet werden. Zur Vermeidung von Pilzvergiftungen bietet die DGfM zudem Aus- und Fortbildungen zum „Pilzsachverständigen“ an, der Pilzsammler fachlich unterstützt.

Amanita phalloides - Grüner Knollenblätterpilz
Bild: M. Piepenbring
In dem Modul „Artenkenntnis und Ökologie der Pilze“ wird fundierte Artenkenntnis von Großpilzen und ökologisches Wissen weiter vertieft. Dabei wird besonderer Wert gelegt auf die verschiedenen ökologischen Nischen der Pilze, ihre Abhängigkeit von Bodentypen und ihre Vergesellschaftung mit Pflanzen.

Amanita muscaria - Fliegenpilz
Bild: M. Piepenbring
Im Modul „Molekulare Bestimmung von Pilzen“ wird die Sequenzierung von DNA als wichtige Methode zur Differenzierung von Arten und Verwandtschaftskreisen thematisiert. Die Teilnehmer werden so in die Lage versetzt, auf Sequenzdaten basierende Bestimmungen und andere Aussagen nachzuvollziehen und kritisch zu hinterfragen.

Ausschnitt aus einem Chromatogramm einer automatischen DNA-Sequenzierung
Bild: M. Piepenbring
Schimmelpilze sind ubiquitär verbreitete Mikropilze und für den Menschen von Bedeutung als Krankheitserreger, Lebensmittelverderber und Materialzerstörer, aber auch als Produzenten bestimmter Nahrungsmittel oder als Konservierungsmittel. Durch moderne Bauweisen erfahren Schimmelpilze zudem als Kontaminanten von Innenräumen eine zunehmende Relevanz.
Unter den Schimmelpilzen gelten etwa 150 Arten als gefährlich für den Menschen, da sie Allergien, Mykosen und andere Erkrankungen hervorrufen oder auf Grund der Bildung verschiedener Naturstoffe toxisch sind. Unerwünschte Pilze an und in Lebensmitteln stellen eine Gefahr für unsere Gesundheit dar, da sie Giftstoffe bilden können, die bei Verzehr zu Vergiftungen und sonstigen gesundheitlichen Beeinträchtigungen führen.
Im Rahmen des Moduls werden Bearbeitungsmethoden und die Bestimmung diverser für den Menschen relevanter Schimmelpilze anhand von Pilzkulturen thematisiert, denn die Verhinderung bzw. korrekte Einschätzung der Gesundheitsrisiken ist unmittelbar mit der Kenntnis der jeweiligen Pilzarten verbunden.

Chromelosporium fulvum
Bild: M. Piepenbring
Die Phytopathogenen Pilze an Nutzpflanzen in Land- und Forstwirtschaft, Garten- und Parkanlagen, sowie im Städtebau sind eine heterogene Gruppe von Pilzen, die Schäden an Pflanzen hervorrufen können. In Fußgängerzonen, Garten- und Parkanlagen ist die Sicherheit von Baumpflanzungen von großer Bedeutung. Ein rechtzeitiges Erkennen und die eindeutige Ansprache der verursachenden Pilzarten ist Voraussetzung dafür, Epidemien pathogener Pilze zu verhindern oder einzudämmen.

Monilia an Kirsche
Bild: M. Piepenbring
Im Modul „Biotechnologie der Pilze“ werden Pilze als Produzenten interessanter Naturstoffe und Biomoleküle thematisiert. Dank ihrer Enzyme können Pilze nahezu alle organischen Materialien und sogar Werkstoffe, die nur einen geringen Anteil an organischer Substanz enthalten, besiedeln. Diese Enzyme sind biotechnologisch von großer Bedeutung. Viele Pilze können komplexe Sekundärmetabolite synthetisieren, die oft eine biologische Aktivität (z. B. Penicillin, Statine, Cyclosporin) aufweisen. Sie können interessante Leitstrukturen für Agrochemikalien oder Medikamente darstellen.

Fermenter zur Kultivierung von Pilzen
Bild: M. Piepenbring
Nahezu alle Pflanzen haben eine Mykorrhiza. Mykorrhizapilze sind weltweit bestimmend für das Pflanzenwachstum und sind damit ökologisch, aber auch wirtschaftlich für Forstbetriebe und im Acker- und Gartenbau äußerst wichtig. Viele Mykorrhizapilze sind zudem geschätzte Speisepilze. Das Modul gibt Einblicke in Anatomie, Morphologie, Physiologie und ökologische Funktion von Mykorrhizen, sowie über kommerziellen Nutzungsformen.

Mykorrhiza
Bild: M. Leberecht
Termine, Anmeldung, Kosten
Termine zu den angebotenen Modulen zur Fachberaterausbildung finden sie in unserem Kalender.
Zulassung zur Ausbildung zum Fachberater für Mykologie, univ. gepr., DGfM (Ausnahme: Modul 1).
Sie wählen die Module aus, die Sie belegen möchten. Anschließend melden Sie sich per E-Mail bei der/dem jeweiligen Modulleiter/in an und schicken Ihre eingescannte Zulassung zur Ausbildung als Anhang mit.
Sollten die Plätze in einem Modul nicht ausreichen, werden Teilnehmer/innen bevorzugt, die in der Ausbildung weiter fortgeschritten sind. Daher sollten Sie die Module (Kurse), die Sie schon erfolgreich abgeschlossen haben, durch die entsprechenden Scheine belegen. Übersenden Sie die Scheine ebenfalls gescannt als Anhang in Ihrer Anmelde-E-Mail!
Bitte beachten Sie, dass für Kurse an der Goethe-Uni und der Uni Tübingen eine Einschreibung als Gaststudent/in an der jeweiligen Universität erforderlich ist.
Die Anmeldefrist für die einzelnen Kurse ist jeweils sechs Wochen vor Kursbeginn.
Über Kosten für die Kurse informieren Sie sich bitte direkt bei den Dozenten. Eine Kostenübersicht erhalten Sie bei der Koordinatorin Lotz-Winter@em.uni-frankfurt.de.
Bei Fragen wenden Sie sich bitte an die Koordinatorin der Ausbildung:
Lotz-Winter@em.uni-frankfurt.de.
Wir wünschen Ihnen viele spannende neue Erkenntnisse im Reich der Pilze!

